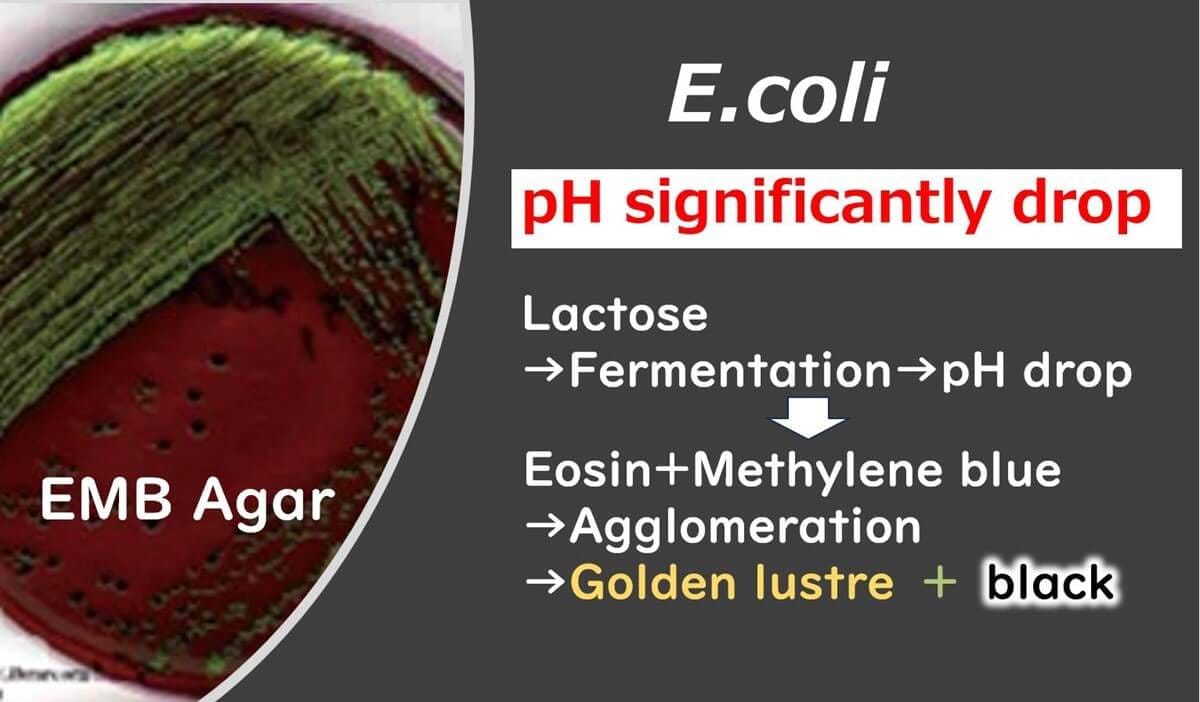

Introduction to Food Microbiology and Safety
Hello Everyone! In this series, we’re diving into the world of foodborne pathogens, starting with Shiga-toxin-producing E. coli (STEC). This bacterium, especially Enterohaemorrhagic E. coli, is known for causing severe illnesses, including symptoms like bloody diarrhoea and serious complications in children. Using a clear, domino-effect approach, we’ll explore its habitat, infection mechanisms, and resistance traits, making each point easy to understand. By the end, you’ll gain valuable insights into the risks associated with specific foods and the lasting health impacts that STEC infections can cause. Let's build a solid understanding together.

Before exploring the details of STEC, we recommend reviewing our introductory article on Gram staining and microbial properties. This foundational knowledge will enhance your understanding of the unique characteristics of this bacterium and its role in food microbiology.
Enterohaemorrhagic E. coli (EHEC) is a specific type of E. coli with unique pathogenic traits. Although it shares many physiological characteristics with regular E. coli, its effects on health can be far more severe. To understand this bacterium's properties, let's examine them step by step, with a focus on its habitat and how this influences its behaviour.
1.Habitat: Enterohaemorrhagic E. coli predominantly resides in the intestines of cattle, a moist and nutrient-rich environment. This setting aligns with its classification as a Gram-negative bacterium.

2.Type of Infection: Being Gram-negative, it’s associated with infectious food poisoning. For a deeper understanding, refer to our foundational article on Gram-positive versus Gram-negative bacteria.
3.Temperature Tolerance: Due to its natural habitat in the warm intestines of cattle, this bacterium does not thrive in low-temperature environments, such as refrigerators (below 8°C).
4.Resistance to Dryness and Heat: Like most Gram-negative bacteria, EHEC is not well-equipped to survive dry or high-heat conditions.
5. Oxygen and Growth: EHEC is a facultative anaerobe, meaning it can grow in environments without oxygen—an adaptation that suits its intestinal habitat.
6.Acid Resistance: Being a facultative anaerobe, EHEC exhibits strong acid resistance. In EMB agar, colonies that appear golden are E. coli, distinguished by their acid tolerance, which causes the pH to lower and dyes like Eosin Y and Methylene Blue to cluster around the colony.

We use something called EMB agar plates for this purpose. Now, here’s the cool part! On these EMB agar plates, only the colonies of bacteria that shine in a golden colour are E. coli! If it doesn’t shine golden, then it’s a different type within the E. coli group.
Now, you might be wondering, why this golden shine? Well, this is because E. coli is especially strong against acids. The surrounding pH of E. coli colonies that form on EMB agar plates is lower compared to other colonies from the E. coli group. As a result, the dyes added to the medium, Eosin Y and Methylene Blue, cluster around the E. coli colonies. This makes the E. coli colonies shine golden around the edges.
Remember, these golden shining colonies signify the presence of E. coli due to their unique ability to withstand acidic environments. Isn’t science fascinating?
7.Drug Resistance: EHEC’s Gram-negative structure includes an outer membrane that provides significant resistance to antimicrobial agents, especially those with hydrophobic functional groups.
So, as we have discussed, Gram-negative bacteria show generally strong resistance to antibacterial agents. It’s because they have this outer layer, and the hydrophilic part of this layer, made of polysaccharides, can repel antibacterial agents that have hydrophobic functional groups. It’s like having a shield that keeps unwanted things away!
8. Selective Growth: To isolate Gram-negative bacteria like EHEC, selective media often include compounds like bile salts and Brilliant Green, which inhibit Gram-positive bacteria.
As you can see, each characteristic follows logically from the previous one, creating a "domino effect" that allows us to build a comprehensive picture of this bacterium’s unique adaptations.
Enterohaemorrhagic E. coli (EHEC) is one of the many serotypes within the E. coli species. While E. coli as a whole encompasses various types, only specific serotypes, like O157 and O26, are capable of causing severe diseases in humans. So, what exactly is a "serotype"?
Since E. coli is a Gram-negative bacterium, it has a distinctive outer membrane on its cell surface. This outer membrane is similar to the cell membrane but differs in structure due to chains of polysaccharides on its surface. These polysaccharide chains are unique to each serotype, serving as identifiers for different E. coli strains. This characteristic component is known as the "O antigen."

Apart from the O antigen, another defining factor is the "H antigen," which reflects differences in the flagellar protein structure. Together, these antigens help in categorizing E. coli into various serotypes.

To determine an E. coli serotype, scientists use a method based on the structural differences in these polysaccharide chains through specific serum reactions.

By leveraging the highly specific nature of antigen-antibody reactions, it's possible to accurately identify specific serotypes within E. coli.

leading to global testing systems that primarily focused on detecting this serotype. However, recent research has shown that other EHEC serotypes also pose significant risks. This has led to a global recommendation to broaden the testing parameters beyond just O157 to identify diverse EHEC serotypes contributing to foodborne illnesses.
Understanding serotypes is like understanding different models of a car—they may look and behave differently, but they are all part of the same "make." Recognizing these "models" within E. coli helps in targeting and combating the wide array of illnesses they can cause more effectively.
Before we dive into the specific pathogenic mechanisms of E. coli, it’s helpful to understand the two general patterns of infection exhibited by infectious foodborne bacteria on intestinal epithelial cells. These bacteria can be broadly categorized into two types based on their infection strategy.
Infectious Toxigenic:
The first type, known as "infectious toxigenic" bacteria, do not invade the intestinal epithelial cells directly. Instead, they produce toxins on the cell surface. For instance, E. coli O157 and Vibrio cholerae follow this toxigenic pathway. Although these bacteria produce toxins, they are not classified as "toxigenic foodborne bacteria" in the traditional sense. Unlike other toxigenic bacteria that produce toxins within the food itself, infectious toxigenic bacteria begin toxin production only upon contact with the surface of intestinal cells. This means that their toxins are not found in the food but are produced within the host during infection. This characteristic defines them as "infectious foodborne bacteria."

Infectious Invasive:
The second type of infection is "infectious invasive," where bacteria actively invade the intestinal epithelial cells. Bacteria like Salmonella and Listeria are well-known examples of this invasive approach. We can refer to these bacteria as "infectious invasive" pathogens because they penetrate the host cells, unlike the toxigenic type that acts from the outside.
In summary, we have two types of foodborne pathogens based on their mechanism: those that make toxins on the cell surfaces without invasion, such as E. coli O157, and those that actually invade our cells, such as Salmonella. These two infection patterns highlight the remarkable diversity of strategies that bacteria have evolved to cause illness, each posing unique challenges in food safety.
Let’s explore how Enterohemorrhagic E. coli (EHEC) infects the human body, a process that often leads to severe symptoms and higher fatality rates compared to other E. coli strains. EHEC releases a powerful toxin known as Shiga toxin, which damages intestinal epithelial cells. This damage leads to significant bleeding in the intestines, and one of the most common symptoms of E. coli O157 infection is bloody diarrhea.

One particularly dangerous aspect of Enterohemorrhagic E. coli is its ability to affect children, who are especially vulnerable due to their weaker immune systems. In severe cases, the Shiga toxin doesn’t just target the intestines—it enters the bloodstream and travels to the kidneys. Once there, the toxin attacks kidney cells using the same mechanism as in the intestines, causing extensive cellular destruction.
The kidneys play a vital role in filtering impurities from our blood. When the toxin damages these cells, it can lead to hemolytic uremic syndrome (HUS), a life-threatening condition that may result in kidney failure or even death. This is especially concerning in young children, who may suffer severe, long-term health impacts if they survive the initial infection.

In summary, Enterohemorrhagic E. coli invades our system by damaging intestinal cells, leading to bloody diarrhea. In severe cases, the Shiga toxin can also affect the kidneys, causing additional health complications, particularly in children. Understanding this infection mechanism is essential for preventing and managing the risks associated with EHEC infections.
When considering the risk of Enterohemorrhagic E. coli (EHEC) infection, certain foods stand out as common sources of contamination. Among these, beef and beef-related products are the primary culprits. Since E. coli bacteria typically reside in the intestines of cattle, they can easily contaminate beef during the slaughter and processing stages if proper hygiene is not maintained.
Vegetables are another food category that can carry a risk, especially those grown near cattle farms. E. coli contamination can occur through environmental factors, such as water run-off from nearby livestock areas, which may carry the bacteria to fields where crops are cultivated.
In simple terms, when considering high-risk foods, it's essential to exercise caution with beef and beef-related products, as well as vegetables grown in close proximity to cattle farming areas. Understanding these sources of risk can help consumers make informed choices to reduce their chances of EHEC infection.

While recovery from an E. coli infection is possible, certain strains, particularly Enterohemorrhagic E. coli (EHEC), can cause lasting damage, especially in young children and vulnerable individuals. A severe complication of EHEC infection is hemolytic uremic syndrome (HUS), which can lead to lifelong kidney dysfunction and, in some cases, necessitates kidney dialysis.
Children infected with EHEC and suffering from HUS may experience persistent impairments, such as high-level brain dysfunction and kidney issues, lasting well beyond the initial infection period. Even adults can face long-term health consequences, including an increased risk of hypertension, due to the damage caused by EHEC’s Shiga toxin.

The long-term effects of EHEC infection highlight the importance of understanding these risks. For affected individuals, these consequences can significantly reduce quality of life. This is why it's essential to take preventive measures against exposure to high-risk foods and to spread awareness about the potential long-term impacts of foodborne infections caused by EHEC.

Discover expert-led lessons in food microbiology designed for professionals and beginners alike.

Bon Kimura, Professor Emeritus at Tokyo University of Marine Science and Technology (TUMSAT), specializes in food microbiology. He obtained his PhD from Kyoto University and became a professor at TUMSAT in 2006, serving as Dean of the Faculty of Marine Science from 2012-2015. Kimura has published over 200 international papers on food safety, pathogens, and spoilage bacteria. He has received multiple awards, including the Japanese Society for Food Microbiology Award (2019). Kimura also served as an editor for the International Journal of Food Microbiology from 2012 to 2024, where he was the principal reviewer for 1,927 papers.

Copyright © Introduction to Food Microbiology and Safety All Rights Reserved.